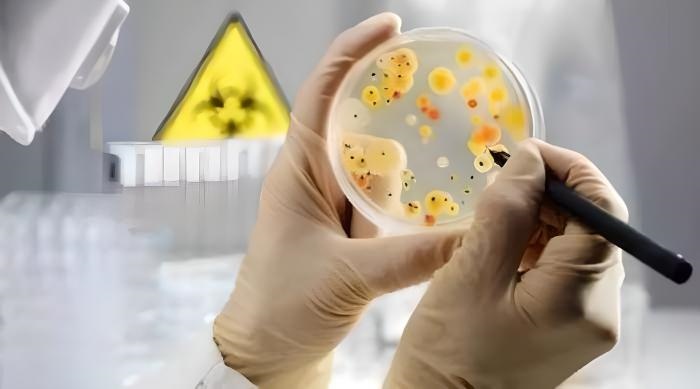
微生物快速檢測技術(shù)

探討食品安全快速檢測技術的發展與應用及法律依據
在現代社會中,食品安全已成為人們生活中的一個重點關注領域。隨著科學技術的快速發展,食品安全快速檢測技術脫穎而出,成為食品監管的有力工具,快速、準確地對食品質量進行評估,并在法律上得到了明確肯定。本文將詳細介紹這些快檢技術,并探討其在食品安全管理中的應用與意義。
一、什么是食品安全
食品安全(food safety)指食品無毒、無害,符合應當有的營養要求,對人體健康不造成任何急性、亞急性或者慢性危害。根據倍諾食品安全定義,食品安全是“食物中有毒、有害物質對人體健康影響的公共衛生問題”。食品安全也是一門專門探討在食品加工、存儲、銷售等過程中確保食品衛生及食用安全,降低疾病隱患,防范食物中毒的一個跨學科領域
二、什么是食品安全快速檢測
食品安全快速檢測是指利用檢測耗材或快速檢測儀器按照有關部門規定的快檢方法,對食品(含食用農產品)包括樣品制備在內,進行某種特定物質或指標短時間內出具檢測結果及對現場食品安全狀況進行初步評判的行為。
通常認為,理化檢驗方法一般在兩個小時內能夠出結果的即可視為快速方法;微生物檢驗方法與常規方法相比,能夠縮短1/2或1/3時間出具具有判斷性意義結果的方法即可視為快速方法;現場快速檢測方法一般在30min內能夠出結果,如果能夠在十幾分鐘內甚至幾分鐘內出具結果的即是較好的方法。
三、食品安全快速檢測技術:
食品安全快速檢測技術主要包括農藥殘留、藥物殘留、添加劑及非食用物質、微生物及重金屬等方面的檢測技術,針對不同的檢測對象,使用不同的檢測方法。
①農藥殘留快速檢測技術
農藥殘留快速檢測技術以其簡便、快捷、易操作的特點,尤其是酶抑制法,在國內外獲得了廣泛的應用。該方法通過檢測植物體內的酶活性來推測農藥殘留量。國際上流行的檢測方法還包括紙片法和分光光度法,兩者均具有操作簡單、檢測迅速等優點,但也存在準確度不高、穩定性差等問題。
②藥物殘留快速檢測技術
藥物殘留快速檢測技術中,ELISA和膠體金免疫測定法廣泛應用于監測獸藥殘留。ELISA雖然準確度較高,但需要專業設備和技術人員,較適合專業實驗室使用。相較而言,膠體金免疫測定法更適合基層應用,具有快速、方便的特點。
③添加劑及非食用物質的快速檢測技術
對于添加劑及非食用物質的快速檢測,常用方法包括目視比色法、分光光度法、紙層析法等。這些方法能夠幫助監管人員快速識別食品中非法添加的各種物質,但也各有利弊,需要根據實際情況選擇合適的檢測手段。
④微生物快速檢測技術
微生物快速檢測技術對食品安全至關重要,傳統的培養分離法耗時且操作復雜。而現代快速檢測技術如顯色培養基法、測試片法、檢測板法等,則可以快速、方便、靈敏地檢測微生物污染的程度,極大地提升了食品安全監管效率。
⑤重金屬快速檢測技術
重金屬快速檢測技術也在食品安全檢測中占據了重要地位。如紫外-可見分光光度法、電化學法等都被廣泛應用于重金屬的檢測中。這些方法具有檢測速率快、準確度高、操作簡單等優勢。
四、食品安全快速檢測方法優劣性:
目前在食品安全監管中應用比較普遍的快檢方法主要有酶抑制法、化學比色法、膠體金免疫層析法等。
(1)酶抑制法主要檢測果蔬中農殘,具有檢測快速簡便、成本低的優點。但是酶抑制法存在以下明顯缺陷:①產品準確率低、假陽性高;②適用范圍小,僅能檢測有機磷和氨基甲酸酯類的農藥;③產品靈敏度低。
(2)化學比色法主要檢測理化指標,具有操作簡便、快速直觀、價格低廉和便攜化等特點。但是化學比色法部分試劑毒性較大,同時存在準確性低、穩定性差、靈敏度低的缺點。
(3)膠體金免疫層析法的最大優點是靈敏度高、準確性好、特異性強,方法的假陽性率和假陰性率可控制在5%以內。但與酶抑制法及化學比色法相比,膠體金免疫層析法開發難度大、檢測成本高。
五、食品安全快速檢測的法律依據
在食品生產與流通的每一個環節,保障食品的安全是至關重要的。隨著技術的進步和監管需求的增加,快速檢測方法并在法律上得到了明確肯定。如今,中國《中華人民共和國食品安全法》和《中華人民共和國農產品質量安全法》均強調了快速檢測方法在食品安全監管中的核心作用,為維護廣大消費者的利益、促進食品產業健康發展提供了有力支持。
①快速檢測方法的法律地位得到了立法的確立。2015年10月1日起施行的《中華人民共和國食品安全法》在第一百一十二條明確指出,縣級以上政府食品藥品監督管理部門可以運用國家規定的快速檢測方法進行食品的抽查檢測。
②從2023年1月1日起施行的《中華人民共和國農產品質量安全法》中規定,同等級的地方人民政府農業農村主管部門有權采納認定的快速檢測方法,執行農產品質量安全的監督抽查。抽查檢測結果確定有關農產品不符合農產品質量安全標準的,可以作為行政處罰的證據。
③國家七部門聯合印發的《食用農產品“治違禁 控藥殘 促提升”三年行動方案》提出,要增強日常巡查檢查的力度,并有效運用快速檢測手段。這表明快速檢測已經成為日常食品安全監管體系不可或缺的一部分,特別是針對性不強和常規農獸藥殘留問題的解決途徑。
④市場監管總局關于規范食品快速檢測使用的意見
鏈接市場監管總局關于規范食品快速檢測使用的意見
六、食品安全快速檢測的重要性
快檢技術的積極意義是不言而喻的。這些技術可用于對流通環節的食品進行抽檢,縮短了檢測時間,提高了檢測效率,顯著降低了食品安全事故的發生率。它們的便攜性使監管人員能夠在現場完成判定,及時地采取預防措施。快速檢測方法在促進食品產業自我糾正和改進方面也扮演了重要角色。通過監管壓力,食品生產企業被鼓勵采取更加科學和規范的生產流程,不斷提升食品安全水平。這無疑促進了整個食品行業的技術進步和質量提升,也增強了消費者對于食品安全的信心。
隨著科技的不斷創新,未來食品安全快速檢測技術將更加先進、準確和普及。隨著檢測方法的改進和成本的降低,快速檢測技術有望成為食品安全監管中更加常規和基礎的手段。實施快速檢測不僅提升了監管效能,同樣也保障了消費者的健康安全,實現了食品生產與消費的可持續發展。快速檢測技術的應用是食品安全領域中的一項重要進展,它推動了整個行業朝著更高標準、更嚴要求的方向發展。未來,我們有望通過這些技術建立起一個更為高效和透明的食品安全監管系統,進一步保護人民群眾的飲食健康。


 脫氫乙酸鈉膠體金檢測卡
脫氫乙酸鈉膠體金檢測卡 磷酸鹽(保水劑)檢測儀
磷酸鹽(保水劑)檢測儀 磷酸鹽(保水劑)快速檢測試劑盒
磷酸鹽(保水劑)快速檢測試劑盒 肉類安全檢測儀
肉類安全檢測儀 多參數水質快速檢測儀
多參數水質快速檢測儀 抗生素殘留快速檢測儀
抗生素殘留快速檢測儀 熒光增白劑檢測儀
熒光增白劑檢測儀 在線紅外水分儀
在線紅外水分儀 近紅外全光譜水分儀
近紅外全光譜水分儀 農藥殘留檢測卡(膠體金法)
農藥殘留檢測卡(膠體金法) 卡爾-費休電量法水分儀
卡爾-費休電量法水分儀 烘干法水分測定儀
烘干法水分測定儀 藥物殘留快速檢測儀
藥物殘留快速檢測儀 瘦肉精快速檢測儀
瘦肉精快速檢測儀 明礬(鋁、硫酸鋁鉀)檢測試劑盒
明礬(鋁、硫酸鋁鉀)檢測試劑盒 水分快速測定儀
水分快速測定儀 手持式ATP熒光檢測儀
手持式ATP熒光檢測儀 ATP生物熒光檢測儀
ATP生物熒光檢測儀 食用油品質快速檢測儀
食用油品質快速檢測儀 食品色素檢測儀
食品色素檢測儀 金標讀數儀
金標讀數儀 熒光定量分析儀
熒光定量分析儀 農藥殘毒檢測儀
農藥殘毒檢測儀 食物中毒檢測箱
食物中毒檢測箱 全能型食品安全檢測箱
全能型食品安全檢測箱 農藥殘留檢測試劑盒(紙片法)
農藥殘留檢測試劑盒(紙片法) 脫氫乙酸鈉檢測儀
脫氫乙酸鈉檢測儀 苯甲酸鈉含量檢測試劑盒
苯甲酸鈉含量檢測試劑盒 過氧化氫(雙氧水)檢測試劑盒
過氧化氫(雙氧水)檢測試劑盒 六通道多功能食品安全檢測儀
六通道多功能食品安全檢測儀 醬油氨基酸態氮檢測儀
醬油氨基酸態氮檢測儀 重金屬鉛快速檢測卡
重金屬鉛快速檢測卡 橡膠固含量檢測儀
橡膠固含量檢測儀 膠體金水產品藥物殘留檢測儀
膠體金水產品藥物殘留檢測儀 全自動微量水分測定儀
全自動微量水分測定儀 赭曲霉毒素A檢測儀
赭曲霉毒素A檢測儀 病害肉檢測儀
病害肉檢測儀 SF-60鹵素水分測定儀
SF-60鹵素水分測定儀 農藥殘留檢測試劑盒
農藥殘留檢測試劑盒 動物疫病檢測儀
動物疫病檢測儀 依維柯食品質量安全檢測車
依維柯食品質量安全檢測車 抗生素藥物殘留檢測儀
抗生素藥物殘留檢測儀 黃曲霉毒素檢測儀
黃曲霉毒素檢測儀 T-2毒素檢測儀
T-2毒素檢測儀 嘔吐毒素熒光定量檢測儀
嘔吐毒素熒光定量檢測儀 真菌毒素熒光定量檢測儀
真菌毒素熒光定量檢測儀 農產品質量安全檢測儀
農產品質量安全檢測儀 便攜式農藥殘留檢測儀
便攜式農藥殘留檢測儀 農藥殘留快速檢測卡
農藥殘留快速檢測卡 便捷式食品安全檢測儀
便捷式食品安全檢測儀
 13560713862
13560713862 微信客服
微信客服
 官方公眾號
官方公眾號